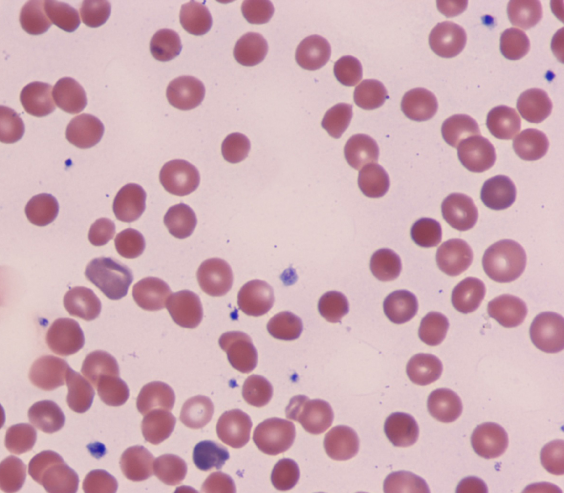

CK- UWSA 1- Block 4
Quiz Summary
0 of 40 Questions completed
Questions:
Information
You have already completed the quiz before. Hence you can not start it again.
Quiz is loading…
You must sign in or sign up to start the quiz.
You must first complete the following:
Results
Results
0 of 40 Questions answered correctly
Your time:
Time has elapsed
You have reached 0 of 0 point(s), (0)
Earned Point(s): 0 of 0, (0)
0 Essay(s) Pending (Possible Point(s): 0)
| Average score |
|
| Your score |
|
Categories
- Not categorized 0%
- Step 1 UWSA 1 – Block 4 0%
| Pos. | Name | Entered on | Points | Result |
|---|---|---|---|---|
| Table is loading | ||||
| No data available | ||||
- 1
- 2
- 3
- 4
- 5
- 6
- 7
- 8
- 9
- 10
- 11
- 12
- 13
- 14
- 15
- 16
- 17
- 18
- 19
- 20
- 21
- 22
- 23
- 24
- 25
- 26
- 27
- 28
- 29
- 30
- 31
- 32
- 33
- 34
- 35
- 36
- 37
- 38
- 39
- 40
- Current
- Review
- Answered
- Correct
- Incorrect
-
Question 1 of 40
1. Question
A 43-year-old homeless man is hospitalized due to abdominal pain. He states that he has burning pain in the epigastric area and has had 2 episodes of vomiting. On admission, blood pressure is 100/70 mm Hg and heart rate is 90/min. Physical examination reveals dry mucous membranes and prominent epigastric tenderness. Laboratory results are as follows:
Aspartate transaminase
320 U/L
Alanine transaminase
152 U/L
Albumin
3.7 mg/dL
INR
0.97
Urine toxicology screen is positive for opiates. On the night of hospitalization, the patient experiences insomnia and restlessness. Temperature is 37.8 C (100 F), blood pressure is 162/94 mm Hg, and heart rate is 120/min and regular. On examination, the pupils are slightly enlarged and equal and reactive to light, and the hands are tremulous. Which of the following is the most appropriate initial pharmacotherapy for this patient?
CorrectIncorrect -
Question 2 of 40
2. Question
A 68-year-old man comes to the office with a cough productive of green sputum for the last week. The patient has had no fevers or chills. He was treated for a viral upper respiratory infection at an urgent care center 2 weeks ago, and was prescribed a cough suppressant that does not seem to be working. He has had no shortness of breath or dyspnea on exertion. The patient does not use tobacco, alcohol, or illicit drugs. Temperature is 37.1 C (98.7 F), blood pressure is 148/92 mm Hg, and pulse is 92/min. Pulse oximetry is 97% on room air. Physical examination shows mild mucosal pallor. There are several palpable, nontender lymph nodes in the cervical chain and axilla. His chest and abdominal examinations are normal other than a slightly prominent spleen tip with deep exhalation. Laboratory results are as follows:
Hemoglobin
9.5 g/dL
Mean corpuscular volume
89 µm3
Platelets
127,000/mm3
Leukocytes
38,800/mm3
Neutrophils
7%
Lymphocytes
92%
Monocytes
1%
Which of the following is most likely to be seen on a peripheral blood smear?
CorrectIncorrect -
Question 3 of 40
3. Question
A 64-year-old man undergoes elective left hemicolectomy for recurrent episodes of diverticulitis and diverticular bleeding. There are no immediate intraoperative complications, but the patient receives 2 units of packed red blood cells on the first postoperative day due to anemia from intraoperative blood loss. On the third postoperative day, he develops confusion. Temperature is 37 C (98.6 F), blood pressure is 90/50 mm Hg, pulse is 110/min, and respirations are 20/min. Oxygen saturation is 96% on room air. The skin around the right subclavian line is normal. There are scattered bilateral crackles at the lung bases that clear with coughing, and cardiac examination is unremarkable. Bowel sounds are present, and the abdomen is soft. The laparotomy wound drains clear fluid that is not grossly erythematous. Neurologic examination is nonfocal. Hemoglobin level is 9.2 g/dL, and leukocyte count is 21,000/mm3. Chest x-ray shows no infiltrates. Urinalysis reveals no bacteriuria, and leukocytes are 7-10/hpf. What is the best next step in management of this patient?
CorrectIncorrect -
Question 4 of 40
4. Question
A 33-year-old pregnant woman at 28 weeks gestation comes to the emergency department with acute-onset, right-side chest pain and shortness of breath. She has no other medical problems. Temperature is 36.6 C (97.8 F), blood pressure is 110/70 mm Hg, pulse is 120/min, and respirations are 26/min. She is diaphoretic and appears to be in distress. Cardiopulmonary examination shows no abnormalities. Extremities are equal in size without swelling. Pelvic examination shows intact membranes and no evidence of vaginal bleeding or cervical dilation. Chest x-ray is normal. Arterial blood gas analysis shows the following results:
pH
7.44
PO2
64 mm Hg
PCO2
32 mm Hg
Ventilation and perfusion scan shows low probability for pulmonary embolism. Which of the following is the most appropriate next step in management of this patient?
CorrectIncorrect -
Question 5 of 40
5. Question
A 24-year-old woman comes to the office for a routine checkup. She has no significant medical history. Blood pressure is 120/74 mm Hg and pulse is 76/min. BMI is 23 kg/m2. The lungs are clear to auscultation. A normal S1 and S2 are heard on cardiac examination. The abdomen is soft and nontender. The spleen tip is palpated in the left upper abdominal quadrant. There is no peripheral edema. A peripheral blood smear is shown on the slide below.
This patient is at greatest risk for which of the following conditions?
CorrectIncorrect -
Question 6 of 40
6. Question
A 65-year-old woman with left index finger stenosing tenosynovitis (trigger finger) has a surgical procedure scheduled for release of the tendon sheath. The procedure is scheduled as the surgeon’s last case of the day in a large, busy hospital. While the patient waits to be taken to the operating room, the surgeon and the assigned circulating nurse each independently verify the patient’s identity and planned procedure, and obtain informed consent. As per standard hospital policy, the patient’s left arm is marked. The surgeon is then notified that, in an administrative effort to accommodate more cases, the procedure will take place in a different operating room with different personnel. This results in a delay in the procedure start time, and a brief time-out is conducted with the new team. During the surgery, the surgeon mistakenly performs surgical release of the left carpal tunnel rather than the left index finger. Which of the following interventions would address a latent error that led to the incorrect procedure being performed?
CorrectIncorrect -
Question 7 of 40
7. Question
A 66-year-old woman comes to the office due to frequent urine leakage that causes her to wear a pad. The leakage is preceded by an urge to urinate, and most of the time she cannot make it to the restroom before urinating. She voids 10-12 times during the day and awakens 2-3 times during the night to urinate. She is very embarrassed as loss of urine has occurred in public places. The patient has no urine leakage during laughing or sneezing. She has no burning or difficulty with urination. The patient has no chronic medical conditions and underwent menopause at age 54. Vital signs are normal. Pelvic examination reveals mild vaginal atrophy. Urinalysis is normal. Which of the following is the best next step in management of this patient’s symptoms?
CorrectIncorrect -
Question 8 of 40
8. Question
An 11-year-old girl is brought to the emergency department by her parents due to a rash that began this morning. She has otherwise been well except for rhinorrhea, cough, and sore throat that developed a week ago and resolved within a few days. Temperature is 37.4 C (99.3 F), blood pressure is 118/70 mm Hg, pulse is 100/min, and respirations are 20/min. Pulse oximetry is 98% on room air. The patient is awake and alert. The oropharynx is clear, and the neck is supple. Cardiopulmonary examination is unremarkable. The abdomen is soft and nontender with no organomegaly. The lower extremity joints have no swelling, erythema, or warmth, but passive range of motion of both knees elicits pain. Extremities are warm and well perfused. Skin examination shows a nontender, nonblanching, deep red, raised rash over the buttocks and lower extremities without a clear pattern. Laboratory results are as follows:
Complete blood count
Hemoglobin
12 g/dL
Platelets
220,000/mm3
Leukocytes
7,500/mm3
Serum chemistry
Sodium
136 mEq/L
Potassium
3.8 mEq/L
Chloride
104 mEq/L
Bicarbonate
24 mEq/L
Blood urea nitrogen
16 mg/dL
Creatinine
0.6 mg/dL
Glucose
100 mg/dL
Immunologic and rheumatologic studies
Erythrocyte sedimentation rate
10 mm/hr
Which of the following is the best next step in management of this patient?
CorrectIncorrect -
Question 9 of 40
9. Question
A 68-year-old man comes to the emergency department due to new-onset back pain, which started this morning. He describes the pain as “intense” and not exacerbated by movement. Medical history is significant for hypertension and coronary artery disease. The patient underwent coronary artery bypass grafting 3 years ago. He smokes a pack of cigarettes daily and consumes alcohol on social occasions. On physical examination, there is a bruit over the right carotid artery. There is no tenderness to palpation of the vertebrae or paraspinal muscles. Lower extremity deep tendon reflexes are symmetric. During ongoing evaluation, he begins to experience dizziness and weakness. His blood pressure drops from 120/85 mm Hg to 90/60 mm Hg and his pulse increases from 78/min to 120/min. Which of the following is the most likely cause of this patient’s back pain?
CorrectIncorrect -
Question 10 of 40
10. Question
A 74-year-old woman comes for follow-up due to persistent pain in her left knee. The patient was initially seen 4 weeks ago for left knee pain. Left knee x-ray at that time revealed joint space narrowing and multiple osteophytes, and as-needed naproxen was initiated. Despite treatment, her pain has worsened and is limiting her activities of daily living. The patient has no history of trauma or falls. Temperature is 36.5 C (97.7 F), blood pressure is 130/80 mm Hg, and pulse is 78/min. BMI is 30 kg/m2. The left knee appears enlarged with mild to moderate effusion and warmth but no erythema. Serum creatinine is 0.9 mg/dL. Which of the following is the best next step in management of this patient?
CorrectIncorrect -
Question 11 of 40
11. Question
A 36-year-old woman, gravida 7 para 3 aborta 3, at 32 weeks gestation comes to the hospital with vaginal bleeding. The patient awoke this morning in a pool of bright red blood and has had some irregular contractions but no constant abdominal pain or leakage of fluid; fetal movement is normal. She has had no vaginal bleeding prior to this morning and has had no prenatal care. She has used methamphetamines intermittently throughout the pregnancy. Blood pressure is 136/78 mm Hg, pulse is 95/min, and respirations are 18/min. Speculum examination reveals a small blood clot in the vagina but no active cervical bleeding. The fetal heart rate monitoring is shown in the exhibit. Blood type is AB positive and hemoglobin is 9.8 g/dL. Which of the following is the best next step in management of this patient?
 CorrectIncorrect
CorrectIncorrect -
Question 12 of 40
12. Question
A 36-year-old man is brought to the emergency department following a high-speed motor vehicle collision. The patient was wearing a seat belt, and front airbags deployed. There was no loss of consciousness. The patient is awake and alert but reports moderate chest pain. His medical issues include obesity and gastroesophageal reflux. His last meal was 8 hours ago. Blood pressure is 140/84 mm Hg, pulse is 116/min, respirations are 24/min, and pulse oximetry is 98% on 4 L oxygen. On examination, there is no obvious external bleeding. There is no cervical spine point tenderness or jugular venous distension. An erythematous seat belt imprint is visible across the chest. There is mild tenderness to palpation at the sternochondral and costochondral joints. Bilateral breath sounds are present and symmetric. Heart sounds are normal without murmurs. The abdomen is soft and nontender to palpation. ECG shows sinus tachycardia. An upright chest x-ray reveals a widened mediastinum but no sternal or rib fractures, pneumothorax, or pleural effusion. Which of the following is the best next step in management of this patient?
CorrectIncorrect -
Question 13 of 40
13. Question
A 25-year-old woman comes to the office due to a painful bump in the genital area. The pain is especially bothersome when she sits, and she cannot have sexual intercourse because of excruciating pain. The patient has multiple sexual partners and typically does not use barrier contraception. She takes oral contraceptives and has no chronic medical conditions. The patient smokes a pack of cigarettes a day and drinks alcohol on weekends. Temperature is 36.6 C (97.9 F), blood pressure is 122/78 mm Hg, and pulse is 90/min. Examination shows a tender, 3-cm, fluctuant mass at the base of the right labium majus, bulging medially into the vagina. Speculum examination is limited by patient discomfort, but no abnormal discharge is seen at the cervical os. The remainder of the pelvic examination is normal. Which of the following is the best treatment for this patient?
CorrectIncorrect -
Question 14 of 40
14. Question
A 26-year-old man is brought to the emergency department by police after being found shouting and behaving aggressively in the street. He is wearing a suit and tie but is rather disheveled. During the interview, he says, “I’m great. They’re just jealous. They know I can make more money than they can. That’s why they brought me here.” During the physical examination, the patient is unable to stop moving and taps his feet constantly. His temperature is 99.1 F (37.3 C), blood pressure is 168/97 mm Hg, and pulse is 121/min. Aside from dilated pupils, the remainder of the examination is normal. He is kept overnight and the next morning his symptoms and vital sign abnormalities have resolved. The patient apologizes for his behavior and asks to be released to go to work. He has had multiple similar emergency department visits over the past year. He says he has no psychiatric history but adds that he always becomes severely depressed for 1-2 days after these episodes. Which of the following would be the most appropriate long-term treatment for this patient?
CorrectIncorrect -
Question 15 of 40
15. Question
A 45-year-old woman comes to the office due to fatigue and weight loss. She has lost 9 kg (20 lb) over the last 6 months. In addition, she has had palpitations, diaphoresis, subjective dyspnea, and amenorrhea during that time. Medical history is notable for vitiligo and 2 uncomplicated cesarean deliveries. The patient has a 25-pack-year smoking history but quit a month ago. Blood pressure is 150/90 mm Hg and pulse is 95/min at rest and 130/min during ambulation. There are no orthostatic blood pressure changes. On physical examination, the sclera is seen above the iris on downward gaze. Separation of the distal part of the fingernails from the nail beds is noted, along with bulbous enlargement of the fingertips. Laboratory results are as follows:
Sodium
138 mEq/L
Potassium
4.1 mEq/L
Chloride
102 mEq/L
Bicarbonate
24 mEq/L
Blood urea nitrogen
10 mg/dL
Creatinine
0.9 mg/dL
Glucose
95 mg/dL
Calcium
10.3 mg/dL
Which of the following is the most likely location of this patient’s pathology?
CorrectIncorrect -
Question 16 of 40
16. Question
A phase I clinical trial is conducted to evaluate the nutritional status of patients with locally advanced pancreatic cancer undergoing chemoradiotherapy who received baseline nutritional assessment and counseling. Fourteen newly diagnosed patients receiving chemoradiotherapy are assessed for baseline clinical nutrition measures (BMI, albumin, weight loss, total energy, and protein intake). Participants completed the self-administered Functional Assessment of Anorexia/Cachexia Treatment (FAACT) questionnaire Anorexia/Cachexia Subscale (A/CS) schedule at baseline and at week 6 of treatment. Which of the following statistical tests is most appropriate to determine whether there is a significant change in A/CS scores from baseline to week 6 of treatment?
CorrectIncorrect -
Question 17 of 40
17. Question
A 35-year-old man is found unconscious on the street. He was recently released from prison after serving time for driving while intoxicated and vehicular homicide. The patient has a history of substance use disorder with multiple illicit drugs and previous drug overdoses. Blood pressure is 90/60 mm Hg, pulse is 60/min, and respirations are 6/min. Oxygen saturation is 86% on room air and 91% on 2 L oxygen. Pupils are small. There is no evidence of bruising or trauma on physical examination. Fingerstick glucose is normal. He is given a dose of naloxone with no response. Which of the following is the best next step in management of this patient?
CorrectIncorrect -
Question 18 of 40
18. Question
A 26-year-old woman comes to the emergency department due to a severe, left-sided, throbbing headache for the past several hours. She also has nausea and has vomited twice since the pain began. The patient has had similar headaches in the past but never this severe. While at home, she took one of her sister’s migraine medication without any relief. She has no other medical history. The patient’s vital signs are within normal limits. Physical examination is normal. Noncontrast CT scan of the head is normal. A diagnosis of migraine without aura is made, and the patient receives a single dose of sumatriptan. Several hours later, she becomes disoriented and has a generalized tonic-clonic seizure. Blood pressure is 220/110 mm Hg and pulse is 120/min. This patient’s current condition is most likely due to an interaction of sumatriptan with which of the following medications?
CorrectIncorrect -
Question 19 of 40
19. Question
A 4-year-old boy is brought to the emergency department for evaluation of a skin rash that developed over the past 24 hours. He has had fevers for 5 days. He has a history of epilepsy, and valproic acid therapy was started 4 months ago for seizure management. His parents have chosen to delay his immunizations, and he has no known allergies to medication. Temperature is 40 C (104 F), blood pressure is 90/60 mm Hg, and pulse is 138/min. Physical examination shows bilateral, bulbar conjunctival erythema with limbic sparing and no exudate. Mucous membranes are dry, and the tongue is erythematous with prominent papillae. The posterior oropharynx appears normal. There is erythema of both palms and a faint, erythematous rash on the extremities and trunk. There is prominent bilateral, anterior cervical lymphadenopathy. Laboratory results are as follows:
Complete blood count
Hemoglobin
11.2 g/dL
Platelets
420,000/mm3
Leukocytes
14,000/mm3
Neutrophils
75%
Liver function studies
Aspartate aminotransferase (SGOT)
62 U/L
Alanine aminotransferase (SGPT)
74 U/L
Which of the following is the most important next step in management of this patient?
CorrectIncorrect -
Question 20 of 40
20. Question
A 67-year-old woman comes to the office due to difficulty driving at night for the past several months. She sees halos around streetlights and excessive glare from the headlights of oncoming cars. The patient also has difficulty driving in bright sunlight. Interior daytime vision is fine, and she has needed her reading glasses less often, but reading at night has been worse. Medical history is notable for hypertension and type 2 diabetes mellitus. She has a 20-pack-year smoking history but quit 10 years ago. Which of the following examination findings is most associated with the cause of this patient’s symptoms?
CorrectIncorrect -
Question 21 of 40
21. Question
A 65-year-old man comes to the office for routine follow-up 3 months after a short hospitalization for pneumonia. He feels well and has no acute problems. The patient has a history of hypertension, hyperlipidemia, and knee osteoarthritis. He underwent an emergency laparotomy 5 years ago for blunt abdominal trauma from a motor vehicle collision. He has been on lisinopril and amlodipine for hypertension since his recent hospitalization. The patient smokes a pack of cigarettes daily and drinks alcohol on weekends. Blood pressure is 160/90 mm Hg and pulse is 90/min. Cardiopulmonary auscultation reveals clear lung fields and normal first and second heart sounds. The abdomen is soft, without organomegaly. A well-healed, midline abdominal surgical scar is present. Laboratory results are as follows:
Now
3 months ago
Complete blood count
Hemoglobin
14.4 g/dL
14.1 g/dL
Platelets
500,000/mm3
490,000/mm3
Leukocytes
7,000/mm3
14,200/mm3
Follow-up chest x-ray today shows complete resolution of the left lower lobe consolidation seen 3 months ago. Which of the following is the most likely cause of this patient’s thrombocytosis?
CorrectIncorrect -
Question 22 of 40
22. Question
A 23-year-old nulligravid woman comes to the office for re-evaluation of continued burning with urination over the past 2 months. A month ago, the patient completed a course of trimethoprim-sulfamethoxazole for similar symptoms but had no relief. She has not noticed any vulvar lesions. The patient is concerned as she has a new sexual partner who she suspects has other partners. She uses combined estrogen/progestin pills for contraception. Her last menstrual period was 10 days ago; menses occur every 26 days with heavy bleeding on the first cycle day. The patient has no medical problems and has received all vaccinations. She has no travel history. She does not use tobacco, alcohol, or illicit drugs. BMI is 25 kg/m2. Vital signs are normal. Clean catch urinalysis results are as follows:
Specific gravity
1.022
Protein
negative
Blood
negative
White blood cells
50+/hpf
Nitrite
negative
Urine culture shows no organisms. If untreated, this patient’s condition will most likely result in which of the following?
CorrectIncorrect -
Question 23 of 40
23. Question
A 63-year-old man comes to the office due to shortness of breath on exertion. He can barely walk 1 block without becoming short of breath, and he sleeps with multiple pillows because he has recently become uncomfortable lying flat. The patient describes heaviness in his legs; he has gained 4.5 kg (10 lb) over the past 2 months despite having a decreased appetite. He does not have chest pain or wheezing but has occasional palpitations. Medical history is significant for type 2 diabetes mellitus, hypertension, and hyperlipidemia. The patient had an anterior wall myocardial infarction 10 years ago but has had poor medical follow-up since then. He was taking metformin and aspirin but stopped more than a year ago. The patient is a former smoker with a 35-pack-year history. He does not drink alcohol and is not allergic to any medications. Blood pressure is 134/85 mm Hg and pulse is 75/min and regular. BMI is 30 kg/m2. The patient is not in acute respiratory distress. Physical examination reveals moist mucous membranes and scattered bibasilar lung crackles. The point of maximal cardiac impulse is displaced to the left, and an S3 is heard. The abdomen is soft and nontender to palpation. He has 1+ bilateral pitting ankle edema. Fingerstick glucose level is 144 mg/dL, and serum creatinine is 0.9 mg/dL. After optimal diuresis with loop diuretics, treatment with which of the following medications is most likely to reduce long-term mortality in this patient?
CorrectIncorrect -
Question 24 of 40
24. Question
A 31-year-old woman comes to the clinic due to amenorrhea for the last 6 months after discontinuing oral contraceptive pills. She also has fatigue and occasional headaches that respond to ibuprofen but has no vaginal discharge, abdominal pain, or vision changes. The patient has gained 3 kg (6.6 lb) over the last 4 months despite no changes in diet and exercise habits. She has no chronic medical conditions and has had no surgeries. Family history is significant for breast cancer in her mother that was diagnosed at age 58. Blood pressure is 124/72 mm Hg and pulse is 52/min. BMI is 21 kg/m2. The skin is dry and without lesions. Physical examination shows no masses on breast examination, but nipple compression produces a scant, whitish discharge bilaterally. The remainder of the physical examination, including pelvic and neurologic examination, is normal. Urine pregnancy test is negative. Which of the following is the best next step in management of this patient?
CorrectIncorrect -
Question 25 of 40
25. Question
A 22-year-old primigravid woman at 33 weeks gestation comes to the emergency department due to lower abdominal pain occurring every 4-5 minutes. She had an episode of bloody vaginal discharge earlier this morning. At 26 weeks gestation, the patient was diagnosed with gestational diabetes mellitus that has not been well controlled. Temperature is 36.7 C (98.1 F), blood pressure is 130/80 mm Hg, pulse is 78/min, and respirations are 18/min. The cervix is 3 cm dilated and 50% effaced. The patient is given a medication that significantly decreases contractions. A few hours later, she has a headache and nausea and appears flushed on examination. Repeat blood pressure is 96/62 mm Hg and pulse is 98/min. The patient’s new symptoms are most likely related to which of the following?
CorrectIncorrect -
Question 26 of 40
26. Question
A 6-week-old African American boy appears to breathe rapidly and becomes diaphoretic after breast feeding for 10-15 minutes. Examination reveals bluish discoloration of his nail beds, lips, and tongue. His extremities are warm. Which of the following is the most likely cause of his physical findings?
CorrectIncorrect -
Question 27 of 40
27. Question
A 23-year-old man comes to the emergency department due to severe epigastric pain, nausea, and vomiting after a party. He recalls a similar, but less severe, episode a year ago. The patient has no other medical conditions. He takes no medications and has no allergies. The patient is a graduate student. BMI is 32 kg/m2. Physical examination shows yellowish streaks on his palms. Blood samples appear milky and opalescent. Which of the following medications is most likely to be effective at preventing future episodes of abdominal pain in this patient?
CorrectIncorrect -
Question 28 of 40
28. Question
A 29-year-old woman, gravida 2 para 1, at 30 weeks gestation comes to the emergency department for pelvic pressure and contractions. This morning, the patient began to have increased pelvic pressure and some clear vaginal discharge. Over the next few hours, she developed irregular contractions that have now increased in intensity and frequency. The patient had preterm contractions with her last pregnancy but ultimately had a spontaneous vaginal delivery at term. She has no chronic medical conditions, and her only medications are a prenatal vitamin and an iron supplement for pregnancy-related iron deficiency anemia. Temperature is 36.7 C (98.1 F), blood pressure is 120/60 mm Hg, and pulse is 92/min. Fetal heart rate tracing is normal. Uterine contractions are regular and occur every 5 minutes. Cervical examination shows 3 cm dilation, 80% effacement, and a breech presentation at −3 station. On speculum examination, the membranes are intact. Which of the following is the best next step in management of this patient?
CorrectIncorrect -
Question 29 of 40
29. Question
A 54-year-old woman comes to the office for follow-up. She has gained 5 kg (11 lb) over the past 6 months. The patient has type 2 diabetes mellitus diagnosed 20 years ago. Other medical conditions include mixed hyperlipidemia and hypertension. She takes maximally tolerated doses of atorvastatin, metformin, and lisinopril. Blood pressure is 125/78 mm Hg and pulse is 76/min. BMI is 34 kg/m2. Cardiopulmonary examination is normal. There is 1+ bilateral pitting edema at the ankles. Laboratory results are as follows:
Hemoglobin A1c
8.5%
Serum creatinine
1.5 mg/dL
Estimated glomerular filtration rate
40 mL/min/1.73 m2
Urine albumin/creatinine ratio
1,200 mg/g
Which of the following is the most appropriate next step in management of this patient’s kidney disease?
CorrectIncorrect -
Question 30 of 40
30. Question
A 43-year-old man comes to the office due to an intermittent tingling sensation in his left fourth and fifth fingers. Symptoms have worsened over the last 6 weeks, and the patient has begun to experience weakness in his hand while lifting weights. The symptoms are worse when he talks on his cell phone during the day but usually improve overnight. The patient works for a distribution company and spends most of his day driving to visit clients in the area. Medical history is unremarkable. On examination of the left hand, there is decreased light-touch sensation over the fourth and fifth fingers, hypothenar eminence, and medial dorsum of the hand. Which of the following is the most likely site of nerve compression in this patient?
CorrectIncorrect -
Question 31 of 40
31. Question
A 13-month-old boy is brought to the physician for evaluation of a painless, non-itchy rash that began this morning. The boy had a fever over the past 3 days, but it resolved on its own today. He has not been exposed to new foods, clothing, lotions, or body washes. He has been more “fussy” than usual but has maintained a good appetite and has no other symptoms. He takes no medications and his vaccinations are up to date. Vital signs are normal. Examination shows a well-appearing infant with blanching, pink macules on his neck, back, abdomen, and chest. No vesicles are present. The rest of his examination is normal. Which of the following organisms is the most likely cause of this patient’s condition?
CorrectIncorrect -
Question 32 of 40
32. Question
A 42-year-old woman comes to the office due to difficulty swallowing. She states that food is “sticking” in her chest, and she has lost 5 kg (11 lbs) over the last 2 months. She has no known medical problems. Her mother has breast cancer and her aunt died of ovarian cancer. Upon further questioning, she says that she has extreme sensitivity to cold. She always wears leather gloves because even mild cold temperature can provoke severe burning and paleness of her fingers. The latter finding can be treated with which of the following?
CorrectIncorrect -
Question 33 of 40
33. Question
A 24-year-old man is brought to the emergency department due to recurrent, generalized tonic-clonic seizures. The patient has a history of seizure disorder and stopped taking his antiepileptic medication 2 months ago. Over the weekend, he consumed alcohol during a party and subsequently experienced 3 episodes of generalized tonic-clonic seizure at home. The patient had 2 more seizures in the ambulance that were not controlled by intravenous lorazepam. In the hospital, he has 1 more seizure before receiving intravenous fosphenytoin. On examination, the patient is afebrile; blood pressure is 120/70 mm Hg, pulse is 90/min, and respirations are 16/min. He is confused and somnolent. Cardiopulmonary examination is normal. The abdomen is soft and nontender. A Foley catheter is placed, which drains 100 mL of dark red urine. The urinalysis and microscopy will most likely reveal which of the following?
Option
Blood
RBC /hpf
WBC /hpf
Casts
A
1+
10–20
10–50
muddy brown
B
2+
0–5
1–2
pigmented
C
2+
10–20
1–2
red blood cell
D
none
0–5
1–2
none
E
none
0–5
10–20
white blood cell
CorrectIncorrect -
Question 34 of 40
34. Question
A 22-year-old man comes to the emergency department due to diffuse swelling. The man has cystic fibrosis, and after being hospitalized for a pulmonary exacerbation a few weeks ago, he noticed mild swelling around both ankles. The swelling has worsened in the last week, and the patient’s weight has increased by 5 kg (11 lb). He has also developed some difficulty breathing. Temperature is 37.2 C (99 F), blood pressure is 120/76 mm Hg, pulse is 120/min, and respirations are 30/min. Pulse oximetry is 92% on room air. Cardiac examination shows tachycardia. Jugular venous distension is present. Lung sounds are coarse bilaterally. The abdomen has ascites but no tenderness to palpation. The liver is 3 cm below the costal margin. There is 3+ pretibial pitting edema. The results of liver function studies are as follows:
Albumin
3.3 g/dL
Total bilirubin
0.8 mg/dL
Aspartate aminotransferase (SGOT)
63 U/L
Alanine aminotransferase (SGPT)
74 U/L
Which of the following is the most likely cause for this patient’s edema?
CorrectIncorrect -
Question 35 of 40
35. Question
A 31-year-old woman, gravida 2 para 2, comes to the clinic for a routine examination and contraception counseling. The patient’s medical history is significant for hypertriglyceridemia. She recently started a weight loss program involving regular exercise and a predominantly vegetarian diet. The patient does not use tobacco, alcohol, or recreational drugs. Her mother died of ovarian cancer at age 64 and her sister had cervical cancer at age 37. Her father had type 2 diabetes mellitus and died of a myocardial infarction at age 54. BMI is 33 kg/m2. Vital signs and physical examination are normal. The patient asks about the risks and benefits of various contraception methods. Regular use of combined oral contraceptives decreases the risk of which of the following?
CorrectIncorrect -
Question 36 of 40
36. Question
The following vignette applies to the next 2 items. The items in the set must be answered in sequential order. Once you click Proceed to Next Item, you will not be able to add or change an answer.
A 59-year-old man comes to the emergency department after 2 episodes of loss of consciousness. His wife, who witnessed the episodes, reports the patient suddenly became limp and collapsed to the floor while eating dinner. He did not respond for about 1 minute before spontaneously regaining awareness. The patient exhibited no abnormal movements and was not confused after regaining consciousness. He had another similar event 2 hours later while watching television lying supine in his bed. The patient had no chest pain, dyspnea, nausea, or lightheadedness prior to the events but reports several bouts of diarrhea over the past 48 hours that he attributes to food poisoning. Medical history is significant for hypertension and coronary artery disease treated with stenting 3 years ago. He also has paroxysmal atrial fibrillation and underwent cardioversion 2 months ago, after which he started taking sotalol for maintenance of sinus rhythm. In the emergency department, the patient is asymptomatic. Blood pressure is 130/90 mm Hg and pulse is 85/min with a regular rhythm. Physical examination reveals clear lungs, normal heart sounds, a nontender abdomen, and no extremity edema.
Item 1 of 2
Which of the following is the most likely underlying cause of this patient’s transient loss of consciousness?
CorrectIncorrect -
Question 37 of 40
37. Question
Item 2 of 2
While being evaluated in the emergency department, the patient experiences palpitations and mild dyspnea but remains hemodynamically stable. The rhythm strip from cardiac telemetry monitoring is shown in the exhibit. Which of the following is the best initial treatment for this patient?
 CorrectIncorrect
CorrectIncorrect -
Question 38 of 40
38. Question
A 37-year-old woman comes to the office due to 6 weeks of pain and paresthesia in her hands. The symptoms are present bilaterally but more severe in the right hand. There are no skin color changes, and the hands feel slightly better when placed under warm running water. The patient works from home as a graphic designer. She has been using a wrist splint for the past 2 weeks with minimal relief of symptoms. Vital signs are normal. BMI is 23 kg/m2. The neck is supple with normal range of motion. There is no lymphadenopathy or thyromegaly. Upper extremity sensation and deep tendon reflexes are normal and symmetric. The patient is instructed to hold her wrists in full flexion with the dorsum of her hands pressed together; after 1 minute she reports reproduction of the pain and tingling. Which of the following is the most appropriate next step in management of this patient?
CorrectIncorrect -
Question 39 of 40
39. Question
A 32-year-old woman is brought to the emergency department due to progressive vision impairment in her right eye. She has had discomfort in her right eye since last night, and her vision became blurry after breakfast. The patient has never experienced similar symptoms. She has occasional headaches but no focal weakness or numbness. Over the past 6 months, she has had several episodes of numbness and tingling on the right side of her right face. Blood pressure is 130/85 mm Hg and pulse is 85/min and regular. Visual acuity is reduced in the right eye, and funduscopic examination is unremarkable. Which of the following is the most likely cause of this patient’s symptoms?
CorrectIncorrect -
Question 40 of 40
40. Question
A 67-year-old woman comes to the emergency department due to an episode of vision loss in the right eye. The patient was at a movie theater when vision in her right eye suddenly became “dim” for approximately 10 minutes. Her vision has now recovered, but she remains very concerned. The patient has never had similar symptoms but does report occasional headaches. She has had no focal weakness or numbness. Medical history is significant for coronary artery disease, hypertension, and type 2 diabetes mellitus. Blood pressure is 130/85 mm Hg and pulse is 65/min and regular. There is a right-sided carotid bruit. Neurologic and funduscopic examinations are unremarkable. Which of the following is the most likely cause of this patient’s symptoms?
CorrectIncorrect
